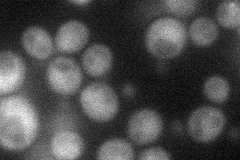
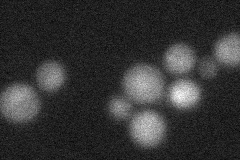
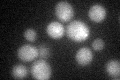

View description
Catalytic subunit of the COP9 signalosome (CSN) complex that acts as an isopeptidase in cleaving the ubiquitin-like protein Nedd8 from SCF ubiquitin ligases; metalloendopeptidase involved in the adaptation to pheromone signaling
Localization:
Intensity:
Fold change:
Significance:
-
C’ GFP library in SD

cytosol19.43 -
N' NOP1pr-GFP in SD
cytosol35.1695 -
N' TEF2pr-mCherry in SD
nucleus15.1315 -
N' NATIVEpr-GFP in SD

below threshold24.3665 -
N' TEF2pr-VC and Cyto-VN in SD

below threshold25.7681 -
C’ GFP library in SD+DTT
cytosol16.670.85No -
C’ GFP library in SD+H2O2

cytosol16.470.84No -
C’ GFP library in Starvation Media

cytosol18.320.94No -
C’ GFP library on the background of Pup2-DaMP

cytosol -
C’ GFP library on the background of CCT mutant

cytosol19.48561.00203No
